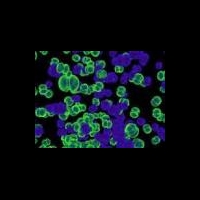
Бактерии используют наночастицы, созданные человеком

Уважаемые коллеги! Приглашаем Вас и Ваших коллег принять участие в 4-й
В НИИ СП им. Н.В. Склифосовского провели пересадку легких пациентке с муковисцидозом. Программа трансплантации легких, успешно стартовавшая в НИИ СП им. Н.В. Склифосовского в прошлом году, п
Watch the INTRABEAM IORT Procedure for Breast Cancer
найти-врача.рф это рекомендательный сервис по выбору врача и медучреждений, первый в России.
Выберите свой город, например, Москва.
На сайте необходимый специалист ответит на Ваш вопрос онлайн, даст совет и осуществит запись на прием для проведения консультации, так же можете узнать возможен ли вызов на дом. После того как врач проведет осмотр, либо вы посетите медучреждения из каталога найти-врача.рф, обязательно оставьте свои отзывы, помогите сделать выбор другим.
Вы можете найти адреса и телефоны интересующих Вас медучреждений.
Поиск врача и мед учреждения - большая и ответственная работа, в которой найти-врача.рф станет Вашим первым помощником.
Врач же может найти на сайте найти-врача.рф признание пациентов и список вакансий.
Новости
Бактерии используют наночастицы, созданные человеком
Рост числа различных устойчивых к воздействию антибиотиков супербактерий, наблюдаемый в последнее время, может быть следствием всё возрастающих объёмов использования наноматериалов в водоочистных технологиях. На это прямо намекают результаты исследования, представленные на текущей неделе в журнале Proceedings of the National Academy of Sciences. Специалисты из Института здоровья и гигиены окружающей среды города Тяньцзинь (Китай) сообщают, что наночастицы алюмогеля (Al2O3) способствуют 200-кратному ускорению развития устойчивости к действию антибиотиков среди различных бактерий, сообщает информационный сайт «Компьютерра–Онлайн».
Появление этих смертоносных бактериальных штаммов связывается с неправильным, неразумным, использованием антибиотиков в медицине, особенно в кормах для животных, когда попадание остаточных количеств антибиотиков в окружающую среду (путём, например, их натурального вывода из организма) приводит к ситуации упрощённого распространения генов резистивности среди бактерий.
А теперь учёные показали, что переносу генов резистивности способствуют остаточные количества наноматериалов в воде, — причём наноразмерный алюмогель проявляет наибольшую эффективность в этом весьма чёрном деле.
Наноразмерная модификация этого недорогого адсорбента всё чаще используется в качестве фильтрующего материала для удаления загрязнений из воды, чему способствует его развитая (по сравнению с обычным алюмогелем) поверхность; в ближайшее время можно ожидать лишь дальнейшего роста объёмов его применения. Более того, уже сегодня в США наноалюмогель является одним из двух (!) самых популярных наноразмерных материалов.
Используя метод электронной микроскопии, китайские исследователи обнаружили, что наноалюмогель, повреждая клеточные мембраны бактерий, активирует образование мостиковых связей между клетками — один из необходимых предварительных этапов сложного процесса переноса генетического материала между бактериями.
Кроме того, наночастицы влияют на экспрессию генов, управляющих процессом генного переноса. Выяснилось, что наноалюмогель ускоряет перенос мобильного генетического материала от E.coli к бактерии Salmonella в 200 раз по сравнению с теми же участниками, но без помощи наночастиц. Точно так же активируется перенос генетического материала между другими видами и штаммами бактерий.
Вывод прост: прежде чем начинать широкомасштабное использование новейших материалов, особенно таких во всех отношениях необычных, как наноматериалы, необходимо всестороннее и долговременное тестирование всех возможных и невозможных последствий их применения для человека и окружающей среды. Ведь сколько твердили миру... а грабли по-прежнему бьют по лбу.
Источник: материалы ABC Science и «Компьютерра–Онлайн».
Есть мысли на тему новости? Поделитесь!
Другие новости
С 1 июня в аптеках на территории РФ запрещена безрецептурная продажа кодеинсодержащих препаратов
Формирование оплаты труда теперь включает 3 составляющих: должностной оклад, компенсационные выплаты; фонд стимулирующих выплат
В Минздраве отчитались о создании проекта нормативной документации, регламентирующей порядок диспансеризации населения уже в 2013 году
Вопрос финансирования здравоохранения не оставляет равнодушных. В интервью российским СМИ Дмитрий Медведев рассказал о консолидированном бюджете
Глава российского Минздрава посетила с рабочим визитом ГКБ 64 и ГКБ 1 города Москвы, а также приняла участие в рабочем совещании